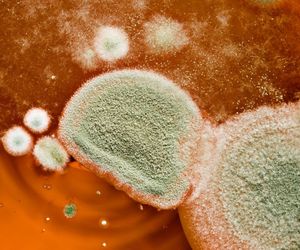

Urazy, wypadki
Urazy i wypadki mogą zdarzyć się każdemu z nas w najmniej spodziewanym momencie. Szczególnie często są konsekwencją wypadków komunikacyjnych i towarzyszą pracownikom wykonującym prace fizyczne. W nagłych przypadkach niezwykle ważna jest pierwsza pomoc przedmedyczna, dlatego warto wiedzieć, jakie działania podjąć przy typowych wypadkach zanim na miejscu zjawi się pogotowie. Działając szybko i sprawnie można ustabilizować stan zdrowia poszkodowanego, a nawet uratować cudze życie.